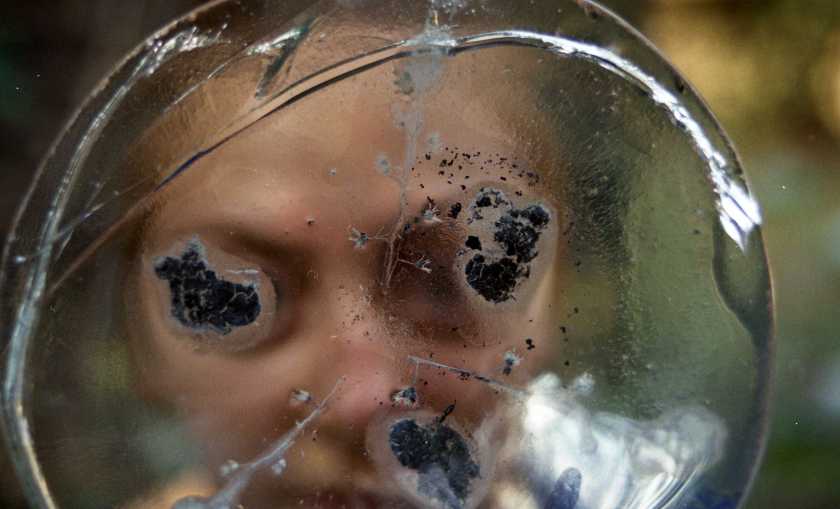

Recording of nomadic song for graduation work. Blues guitar by Ward Blokland, vocal recording by Kaz Holmes-Moorhouse
A project examining symbolic folk imagery and nomadic necessities translated into art objects. A bowl, a bag, a covering, a trailer. All handmade from recycled materials.